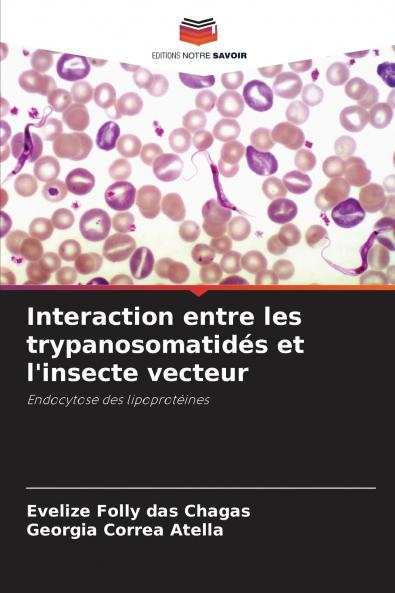
Interaction entre les trypanosomatidés et l'insecte vecteur

Paperback
₹3943
(All inclusive*)
Delivery Options
Please enter pincode to check delivery time.
*COD & Shipping Charges may apply on certain items.
Review final details at checkout.
Looking to place a bulk order? SUBMIT DETAILS
About The Book
Description
Author(s)
Sur le continent américain deux espèces de trypanosomes ont une incidence et une importance médicale importantes Trypanosoma cruzi et Trypanosoma rangeli. Ces deux parasites utilisent des hôtes invertébrés membres de la famille des Reduviidae en particulier Rhodnius prolixus. Au cours de son cycle de vie T. rangeli traverse l'épithélium intestinal et envahit l'hémolymphe de l'insecte tandis que T. cruzi reste dans la lumière intestinale du vecteur. Dans la présente étude nous démontrons pour la première fois la capture de la lipophorine (Lp) qui est la principale particule de transport des lipides dans l'hémolymphe de l'insecte par ces trypanosomes.
Delivery Options
Please enter pincode to check delivery time.
*COD & Shipping Charges may apply on certain items.
Review final details at checkout.
Details
ISBN 13
9786202370363
Publication Date
-11-08-2025
Pages
-80
Weight
-122 grams
Dimensions
-152x229x4.87 mm